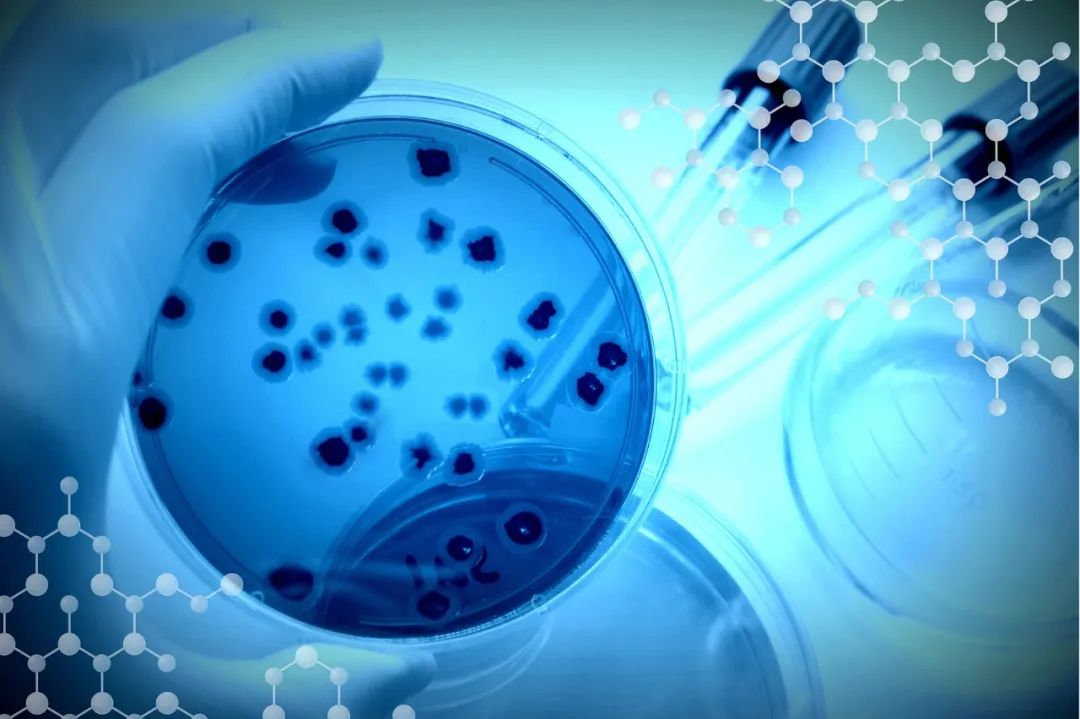

冷链行业的"守护神"
康然创氧抗菌塑料
在食品安全背后的力量
在冷链行业,食品安全与保存是重中之重。随着科技的发展,一种新型材料——抗菌塑料正逐渐成为这个行业的"守护神"。
今天,让我们深入了解这种神奇的塑料如何助力冷链行业,守护我们的食品安全。


冷链行业面临的挑战

在冷链物流中,食品的保存是关键。从生产、运输到销售,每一个环节的温度控制都至关重要。
然而,细菌、霉菌等微生物的存在常常成为食品腐败的"元凶"。这些微生物不仅会影响食品质量,还会对消费者的健康构成威胁。如何在保证温度的同时,有效抑制微生物的生长,成为冷链行业的一大挑战。
02
康然创氧抗菌塑料的崛起

附着力对比

解决了抗菌材料在塑料中难以分散均匀得问题。

解决了传统材料抗菌效果差问题。

可以根据不同材料需求调节缓释性的技术。
面对这一挑战,康然创氧抗菌塑料应运而生。这种新型塑料材料通过加入抗菌母料,有效抑制细菌、霉菌等微生物的生长,大大延长食品的保存期限。与传统塑料相比,抗菌塑料在保持食品新鲜度和安全性方面具有显著优势。

康然创氧抗菌塑料,多场景应用
冷藏设备的内部结构和包装材料是细菌滋生的"重灾区"。使用抗菌塑料制作冷藏设备的内部结构和包装材料,可以有效抑制细菌生长,确保食品长时间保持新鲜。

物流容器:
在食品运输过程中,物流容器是关键。使用抗菌塑料制作物流容器,不仅能有效防止食品被细菌污染,还能大大降低食品在运输过程中的损耗。

销售展示柜:
销售展示柜是食品与消费者直接接触的场所。使用抗菌塑料制作展示柜的内部结构和陈列架,不仅使食品保持新鲜,还能为消费者提供一个更加安全、卫生的购物环境。




康然创氧抗菌塑料的出现,为冷链行业带来了革命性的变革。它不仅延长了食品的保存期限,还为消费者提供了一个更加安全、健康的食品环境。
面对未来,我们有理由相信,随着科技的不断进步,康然创氧抗菌塑料将在冷链行业中发挥更加重要的作用,成为守护食品安全的强大后盾。



